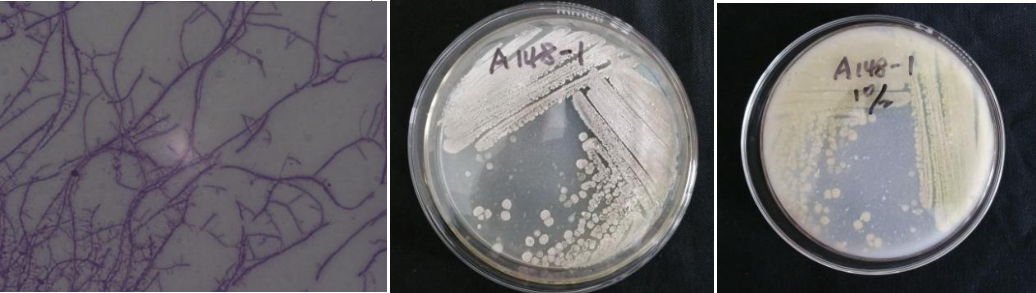

Loading...
| StrainNO | A148-1 |
| Classification | Demetria |
| 16s rDNA sequence | GGTTGCTTAACACATGCAAGTCGAACGATGATGCCCGAGCTTGCTCGGGTGGATTAGTGGCGAACGGGTGAGTAACACGTGAGTA ACCTGCCCTTCACTCTGGGATAAGCCTGGGAAACTGGGTCTAATACTGGATATGACGGCGCACTGCATGGTGTGTTGTGGAAAGA TTTTTTCGGTGAAGGATGGGCTCGCGGCCTATCAGCTTGTTGGTGGGGTAGTGGCCTACCAAGGCGGTGACGGGTAGCCGGCCTG AGAGGGCGACCGGCCACACTGGGACTGAGACACGGCCCAGACTCCTACGGGAGGCAGCAGTGGGGAATATTGCACAATGGGCGCA AGCCTGATGCAGCGACGCCGCGTGGGGGATGACGGCCTTCGGGTTGTAAACTCCTTTCGCCATTGACGAAGCCCTTCGGGGTGAC GGTAGGTGGAGAAGAAGCACCGGCTGACTACGTGCCAGCAGCCGCGGTAATACGTAGGGTGCGAGCGTTGTCCGGAATTATTGGG CGTAAAGAGCTTGTAGGCGGTTTGTCGCGTCTGCTGTGAAAGCCCGGGGCTTAACTCCGGGTCTGCAGTGGGTACGGGCAGACTA GAGTGTGGTAGGGGAGACTGGAATTCCTGGTGTAGCGGTGAAATGCGCAGATATCAGGAGGAACACCGATGGCGAAGGCAGGTCT CTGGGCCATTACTGACGCTGAGAAGCGAAAGCATGGGGAGCGAACAGGATTAGATACCCTGGTAGTCCATGCCGTAAACGTTGGG CGCTAGGTGTGGGATCCATTCCACGGGTTCCGTGCCGCAGCTAACGCATTAAGCGCCCCGCCTGGGGAGTACGGCCGCAAGGCTA AAACTCAAAGGAATTGACGGGGGCCCGCACAAGCGGCGGAGCATGCGGATTAATTCGATGCAACGCGAAGAACCTTACCAAGGCT TGACATGCACCGGACGACTGCAGAGATGTGGTTTCCCTTTGTGGCTGGTGCACAGGTGGTGCATGGTTGTCGTCAGCTCGTGTCG TGAGATGTTGGGTTAAGTCCCGCAACGAGCGCAACCCTCGTTCCATGTTGCCAGCACGTGATGGTGGGGACTCATGGGAGACTGC CGGGGTCAACTCGGAGGAAGGTGGGGATGACGTCAAATCATCATGCCCCTTATGTCTTGGGCTTCACGCATGCTACAATGGCCGG TACAGAGGGTTGCGAGACCGTGAGGTGGAGCGAATCCCTTAAAGCTGGTCTCAGTTCGGATTGGGGTCTGCAACTCGACCCTATG AAGTTGGAGTCGCTAGTAATCGCAGATCAGCAACGCTGCGGTGAATACGTTCCCGGGCCTTGTACACACCGCCCGTCAAGTCACG AAAGTTGGTAACACCCGAAGCCCATGGCCTAACCAGGTTTTCCTGGGGGGAGTGGTCGAAGGTGGGACTGGCGATTGGGATTAGG TCGTAACAAT |
| Strain Morphology Photos | |
| Morphological Description | The morphology of strain:hyphae branch;bunch;separation without fracture;sporofilament is not obvious;or short;straight;spore small |